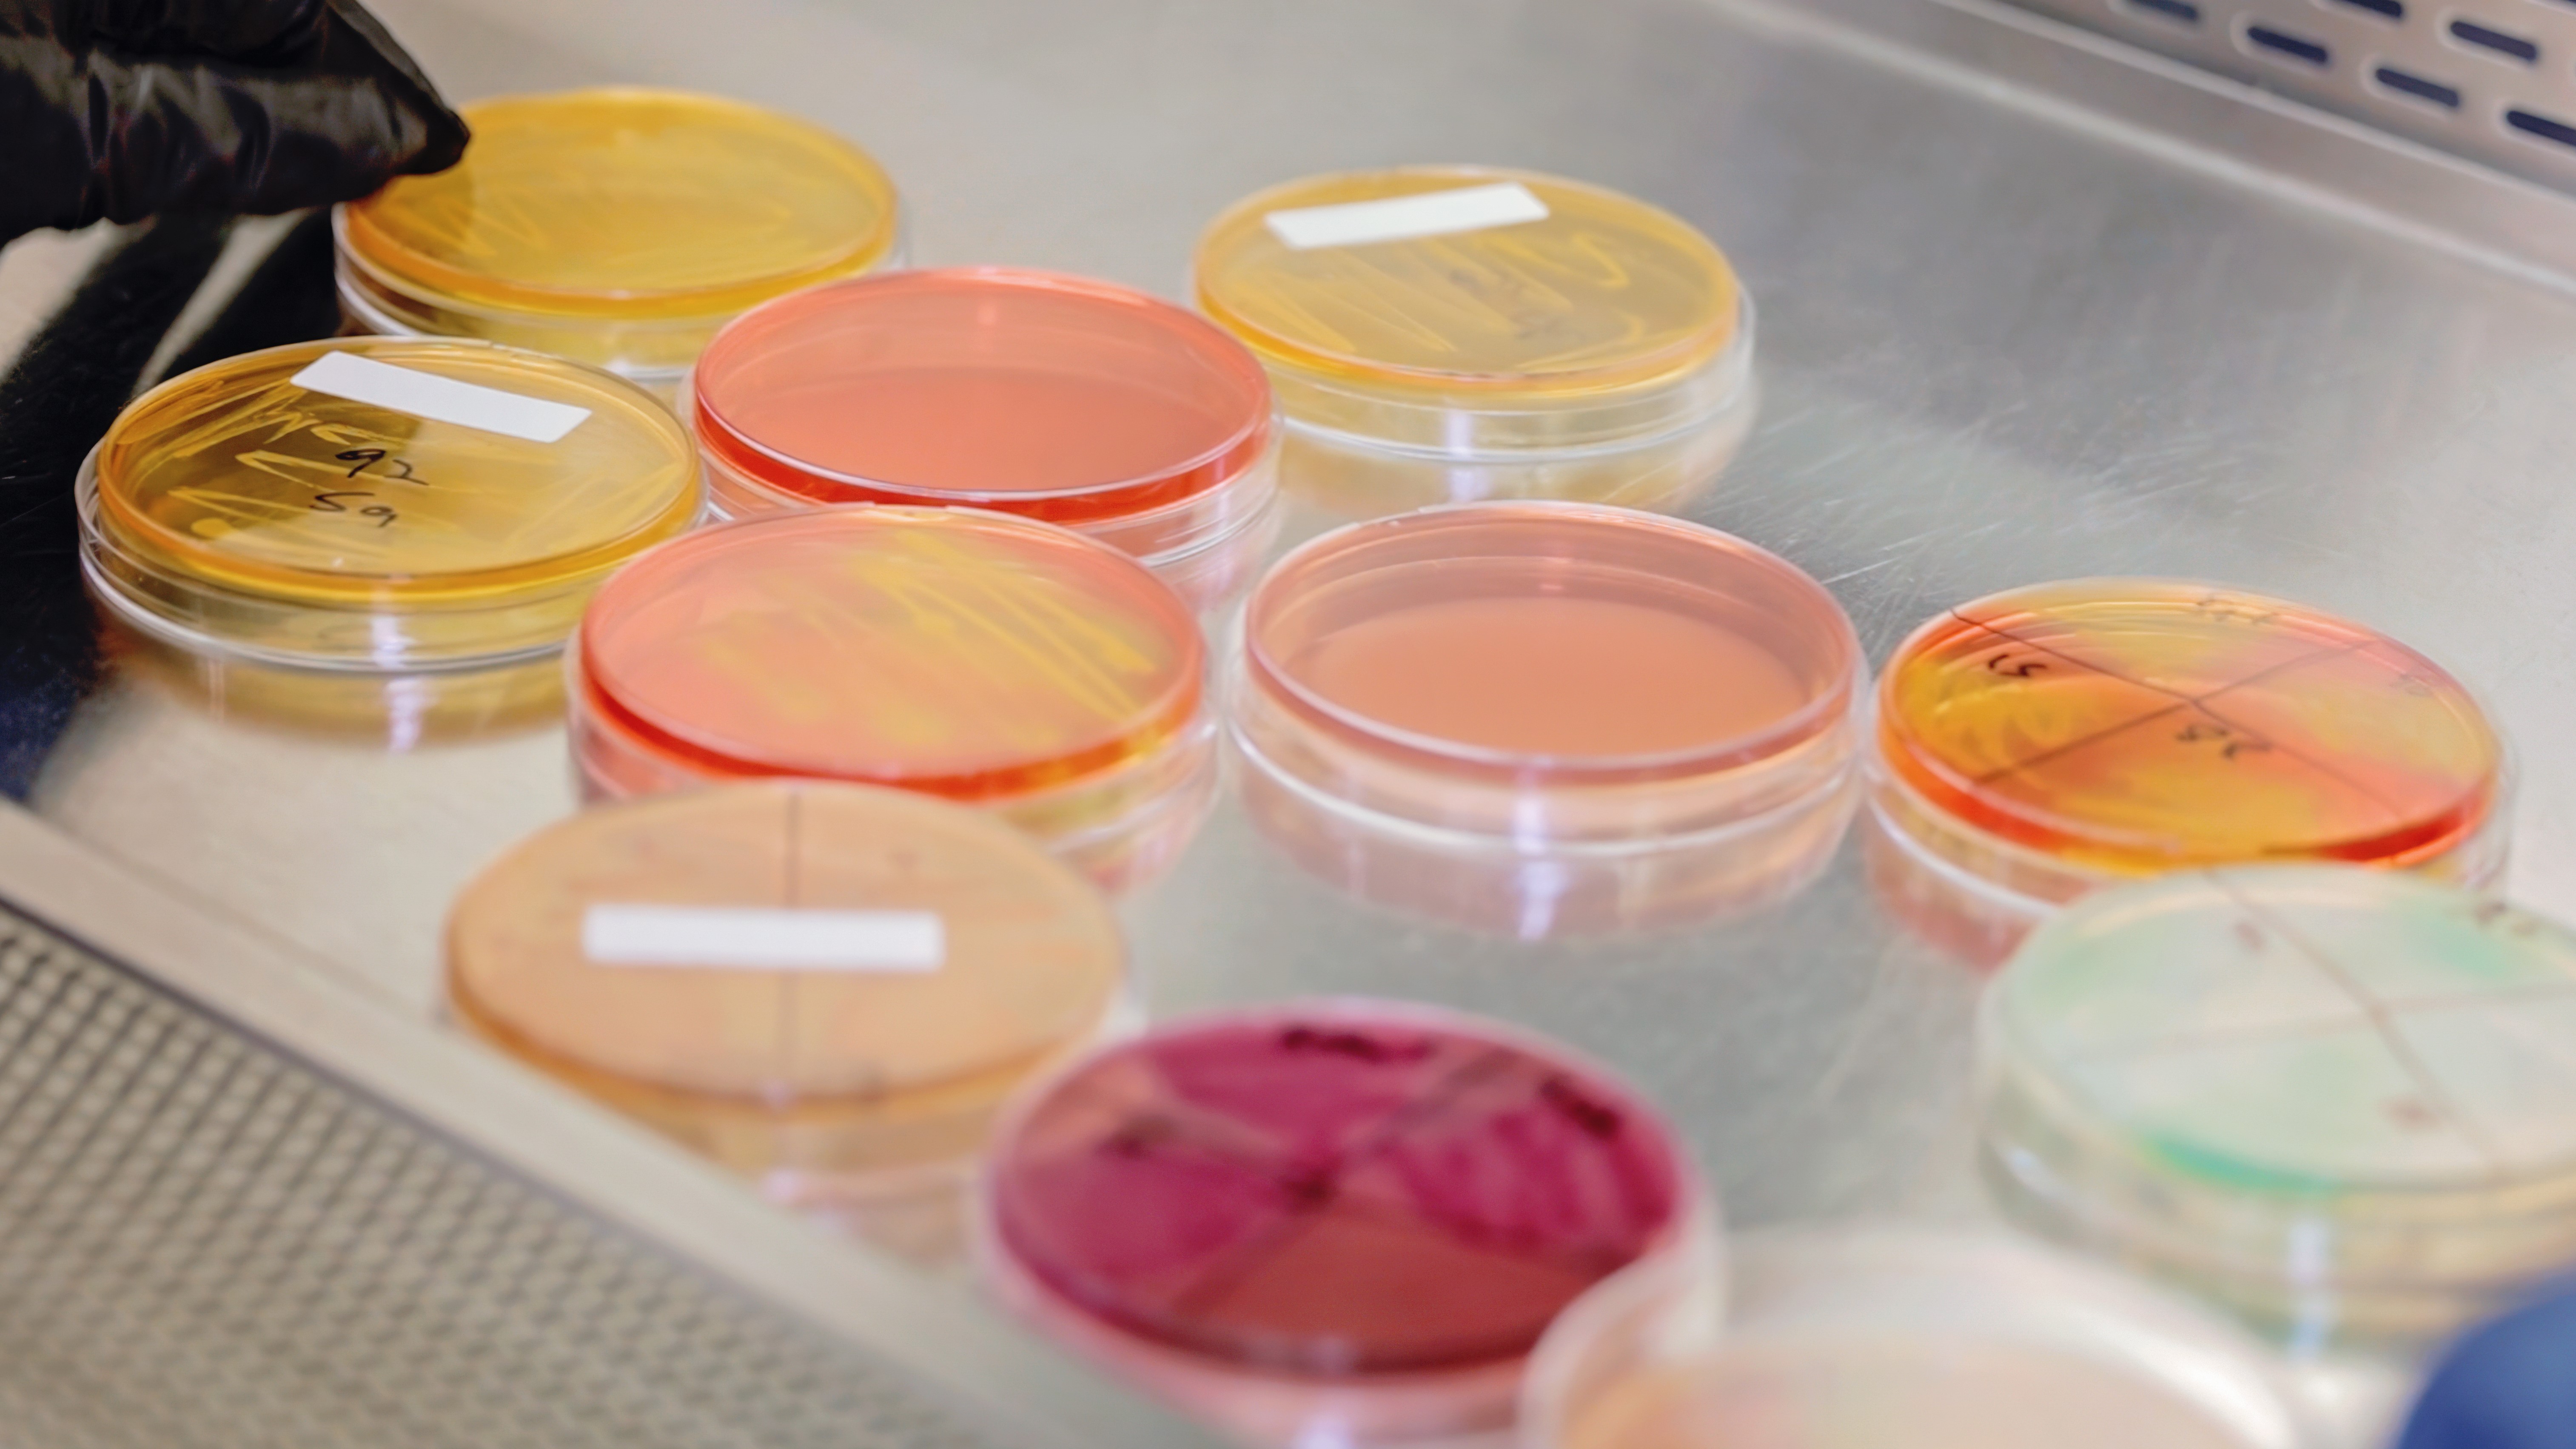
Regulatory Market Access for Cosmetics and Personal Care Products in the Middle East

Navigating the regulatory landscape for importing cosmetics, personal care, and perfume products into the Middle East is crucial for successful market entry. Each country enforces specific regulations, with key oversight from authorities such as the Saudi Food and Drug Authority (SFDA) and the UAE's Ministry of Industry and Advanced Technology (MoIAT).
Trade Facilitation and Speed to Market
Compliance is paramount: products must adhere to stringent standards regarding ingredient safety, labeling, and testing protocols. The regional statutory authorities including municipalities has established their regulatory framework on regional and national standards, ensuring consistent quality and safety across respective markets.
Importers are required to register products, which involves submitting comprehensive documentation, including product formulations, safety data, and evidence of efficacy. Additionally, adherence to Halal standards is mandatory to validate no porcine traces in the ingredients and is increasingly becoming necessary for product differentiation.
To facilitate compliance, businesses can leverage government statutory programs in UAE, KSA, Oman and the region and seek product testing in ISO/IEC 17025 accredited laboratories. These resources not only ensure adherence to regulations but also enhance market credibility.
SGS plays a vital role in expediting trade facilitation and ensuring product compliance in the Middle East. Our rigorous label assessment and product conformity programs help ensure that imported and domestically manufactured cosmetics meet local and international standards. By conducting thorough ingredient evaluations and laboratory testing, SGS generates compliance reports that streamline customs clearance processes, reducing the risk of import rejection.
Product Testing
The state-of-the-art testing laboratories are equipped with the latest technology and staffed by qualified professionals, ensuring consumer safety in line with regional and international standards. The SGS MultiLab facility, covering over 14,000 square feet, supports extensive testing capabilities across various sectors, including cosmetics, food and beverage, and Halal certification.
About SGS
SGS is the world’s leading Testing, Inspection and Certification company. We operate a network of over 2,700 laboratories and business facilities across 119 countries, supported by a team of 99,250 dedicated professionals. With over 145 years of service excellence, we combine the precision and accuracy that define Swiss companies to help organizations achieve the highest standards of quality, safety and compliance.
Our brand promise – when you need to be sure – underscores our commitment to trust, integrity and sustainability, enabling businesses to thrive with confidence. We proudly deliver our expert services through the SGS name and trusted specialized brands, including Brightsight, Bluesign, Maine Pointe and Nutrasource.
SGS is publicly traded on the SIX Swiss Exchange under the ticker symbol SGSN (ISIN CH0002497458, Reuters SGSN.S, Bloomberg SGSN:SW).


